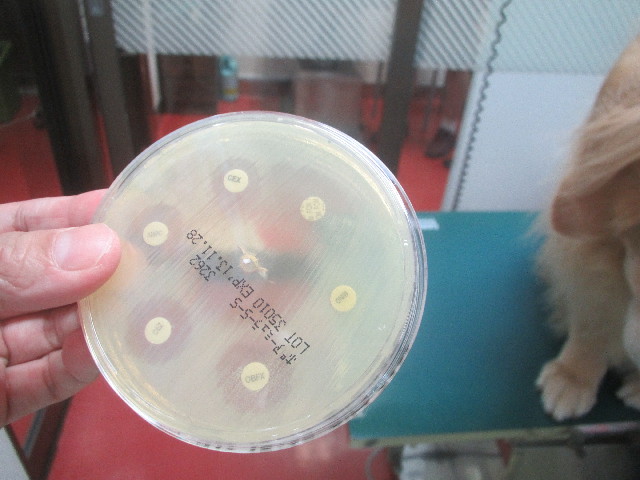
ファイル 3720-3.jpg

朝起きたら、もいちゃんのお股がこんなことになっていました(;□;)!!
(尻尾をよけて、後ろから撮った写真。右の赤くべしょべしょになっているのは右太腿です)
残尿感があって気持ち悪いのか?
おっしっこしたあとのくさい臭いが自分でもイヤなのか?
おしっこのところをなめてしまって毛はベショベショ。
おしっこのところは赤くブンブクリンに腫れさせてしまって、太腿やおなかもなめて赤いです。
まずはイソジンのスクラブでなめて不衛生になってしまったところを洗い、そのあたりの毛をハサミでカットしました。(バリカンで刈ると気になって歩けなくなるので、今回はやや長めにハサミでカット)
培養の結果の電話がかかってくるのを待ちきれずにこちらから獣医さんに電話。
結果が出たとのことなので、早速獣医さんに行ってきました!
だって、一刻も早く効く抗生剤をあげて治してあげたいもの!!
で、獣医さんではまたしても壁を見ていたもいちゃんです(笑)
(獣医さんが苦手だし、他のワンちゃんもいたからね)
今回は21種の抗生剤を調べてくれました(シャーレー3枚分)
で、結局効いていたのは9回目の膀胱炎の時と同じマイシリンのみ。
真ん中の、まわりが大きく透明になっているのがマイシリンです。
(他にも小さく透明になっているものがいくつかありますが、それは効いているようにみえて実は効いていないそうです。よーく見ると透明な所がまだらだったり、紗が入ったように菌が入り込んでいるんです)
すぐにマイシリンを注射してもらいました!(^^)!(毎日とりあえず7日間注射)
あー、なんかホッとしましたぁ。
効く抗生剤さえあげれば(注射すれば)、きっとすぐに良くなって
もいちゃんの残尿感?や、違和感や気持ち悪さをとってあげられるからね!
ちなみに今回のもいちゃんの膀胱炎の菌は、緑膿菌ではありませんでした(前回は緑膿菌)。
もいちゃんに巣くってしまう菌って、一般的な抗生剤が効かなくなった手強いヤツが多いんだねー(汗)
ちなみにマイシリンって、昭和初期頃からある、今では使われる事が少なくなった抗生物質なんだって。
新しい抗生剤にはすっかり耐性菌ができちゃって、古い物だからこそ効くのかもねー。。。
ついでに
●股関節の為のカルトロフェン・ベット注射もしてもらいました(32回目)
●体重は29.72キロ。ついに29キロ台になりました\(^.^)/
(9日間で720g減りました!)
これはチラーヂン効果かもねー♬
獣医さんの帰り、良い風が吹いていたので公園のベンチで涼みました。
今日もらって来た色々。
マイシリンの注射は1日1本。
もいちゃんに欠かせない(笑)、採尿用のシリンジ。
1ケ月分のチラーヂン。
おしっこのところやなめて赤くしてしまったところを洗ってあげるためのスクラブのイソジン。
マイシリンが早速効きだして、違和感やなめて腫れさせてしまったところのかゆみもひいてきたのか?、もいちゃん、今は可愛い寝息をたててスヤスヤとよくねんねしていますd(^0^)b Good!!
あー良かった(*^~^*)
ママも今晩は安心して心置きなく眠れます(いつもガーガー寝ていますが(笑))
もにもに成長日記♪...あいばろ〜ず7頭一緒♪